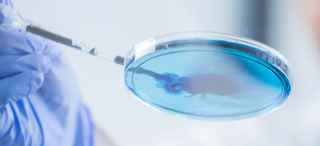
None Hero Image

UT Southwestern’s patient care app – UTSWMyCare – helps you easily manage your health and stay connected to UTSW and your provider, all in a secure and safe environment.
University Hospital Outpatient Laboratory Services
at UT Southwestern Medical Center at Richardson/Plano
3030 Waterview Parkway, 1st Floor
Richardson, Texas 75080 (Directions)
469-291-2821
New Patient Appointment or 469-291-2821